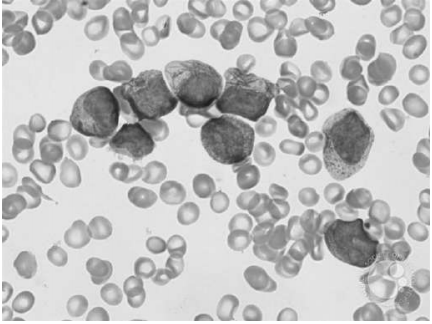
enunciado 1627549-1

Uma paciente de 16 anos de idade apresenta quadro de aparecimento de equimoses em membros inferiores há cerca de três semanas, menorragia, astenia e fadiga. O hemograma realizado indica leucócitos = 500/mm3 , Hb = 6,2 g/dL, Ht = 18,4% e plaquetas = 23.000/mm3 , e o resultado dos exames de coagulação com dosagem de fibrinogênio é de 80 mg/dL. A imunofenotipagem da medula óssea mostra 85% de células com complexidade intermediária a alta e fraca expressão de CD45, correspondendo a blastos que expressavam CD13, CD33 (forte), CD38, CD64 (fraco), CD117 e MPO, sem expressão de CD2, CD11b, CD15, CD34, HLA-DR ou demais marcadores pesquisados. O mielograma pode ser observado a seguir.
Disponível em:<https://imagebank.hematology.org/collection/5910> . Acesso em: 8 jan. 2021.
Com base nesse caso clínico, na imagem apresentada e nos conhecimentos médicos correlatos, julgue os itens a seguir.
A resposta ao tratamento desse tipo de leucemia costuma ser favorável, com baixas taxas de recaída.